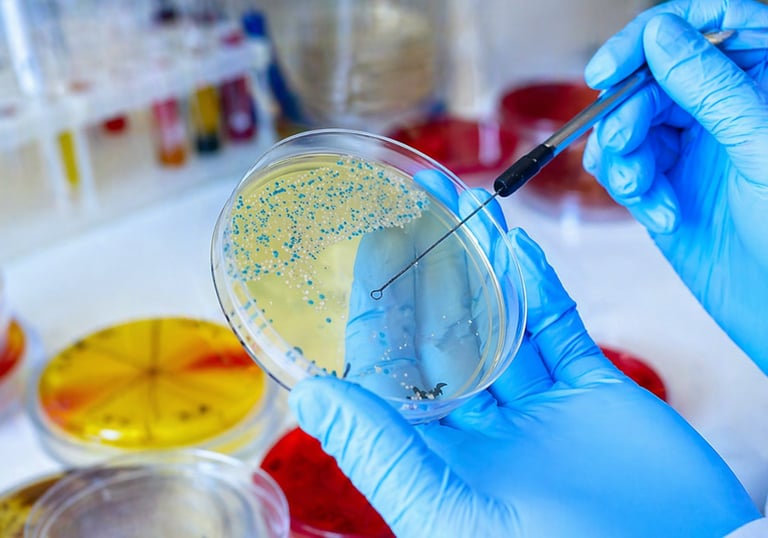

Campanhas e Parcerias Incríveis
Explore nossos projetos e designs

Serviços de Saúde
Informações e orientações sobre saúde pública e alertas de doenças e epidemias.
Telefones Importantes:
SERVIÇO DE ATENDIMENTO MÓVEL DE URGÊNCIA (SAMU) - 192
CORPO DE BOMBEIROS - 193
POLÍCIA MILITAR - 190
DEFESA CIVIL - 199
CENTRAL DE ATENDIMENTO À MULHER NO BRASIL - 180
DISQUE-DENÙNCIA - 181
CENTRO DE VALORIZAÇÃO DA VIDA (CVV) - 188
DIREITOS HUMANOS - 100